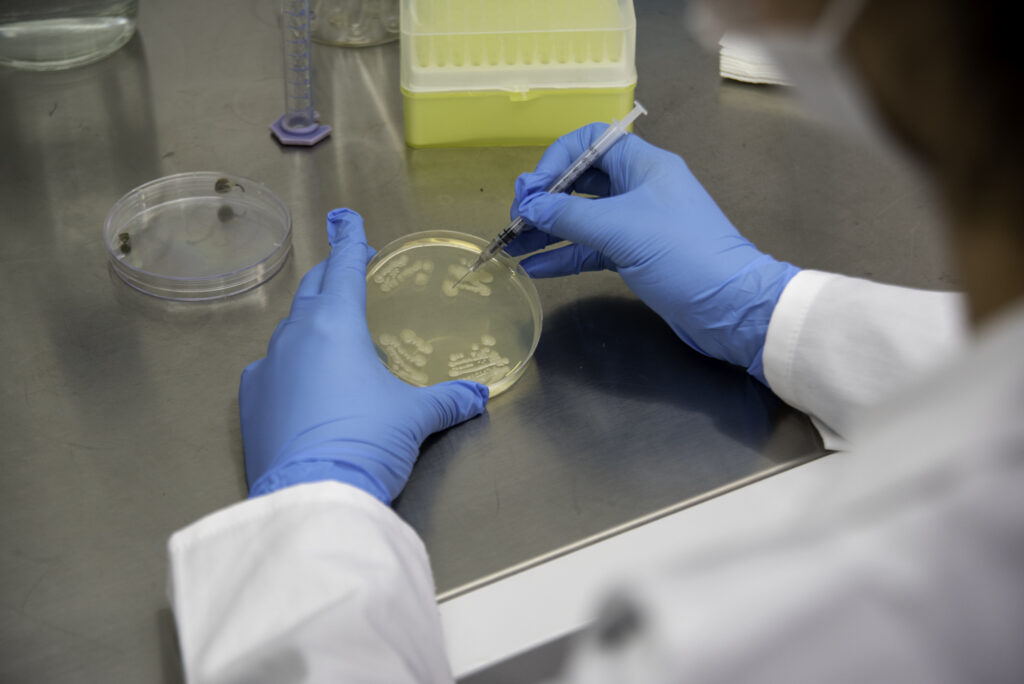

En Aroma Global®, impulsamos la investigación y conservación de microorganismos que contribuyen a una agricultura sostenible y a la restauración de ecosistemas a través de nuestra colección de cepas microbianas.
Entre ellas, destaca Pseudomonas fluorescens, una bacteria del suelo reconocida por su notable capacidad de adaptarse a diversos ambientes, mejorar la fertilidad del suelo y fortalecer el desarrollo vegetal mediante procesos naturales.
Estas bacterias se caracterizan por su alta actividad metabólica y su habilidad para establecer relaciones beneficiosas en la rizósfera, donde influyen en el equilibrio microbiano y en la disponibilidad de nutrientes.
Gracias a su versatilidad, P. fluorescens se ha posicionado como una herramienta clave para avanzar hacia una agricultura regenerativa, menos dependiente de insumos químicos y más alineada con los ciclos naturales del suelo.
🔬 En Aroma Global®, trabajaremos con una cepa de Pseudomonas fluorescens enfocada en la producción de bioinsumos, orientada a:
🌱 Favorecer la asimilación de nutrientes esenciales y mejorar la estructura del suelo.
🌾 Estimular el crecimiento vegetal bajo condiciones de estrés.
💧 Contribuir a la recuperación de suelos degradados mediante procesos naturales de biorremediación.
Nuestro trabajo con esta cepa busca aprovechar las funciones ecológicas y metabólicas de P. fluorescens para desarrollar formulaciones biotecnológicas de nueva generación, capaces de fortalecer la productividad agrícola y, al mismo tiempo, cuidar los recursos naturales.
Cada cepa de nuestra colección es más que un recurso biológico: es un agente de cambio hacia una agricultura inteligente, sostenible y basada en ciencia.
🌿 En Aroma Global®, seguimos transformando la biodiversidad microbiana en innovación biotecnológica para un futuro más sostenible.